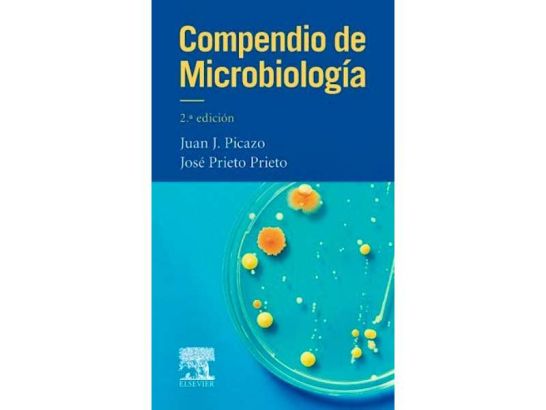

Compendio de Microbiología
¡Aprende microbiología de forma práctica! Compendio esencial en formato de bolsillo para estudiantes de Medicina y Ciencias de la Salud.
Información del fabricante:
Nombre o empresa: Pendiente de actualizar
Email: Pendiente de actualizar
Dirección postal: Pendiente de actualizar
Localidad: Pendiente de actualizar
País: Pendiente de actualizar
Información de la persona responsable:
Nombre o empresa: Pendiente de actualizar
Email: Pendiente de actualizar
Dirección postal: Pendiente de actualizar
Localidad: Pendiente de actualizar
País: Pendiente de actualizar
Advertencias e información de seguridad del producto:
El producto cumple con el Reglamento de Seguridad General de los Productos.
El Compendio de Microbiología es una herramienta imprescindible para estudiantes y profesionales de la salud que desean adquirir un conocimiento sólido y actualizado sobre los fundamentos de la microbiología. Esta nueva edición, dirigida por el Profesor Picazo y el Dr. Prieto, ambos expertos catedráticos en Microbiología, garantiza una revisión completa y una presentación práctica de los conceptos esenciales que son clave en el campo de la microbiología.
CARACTERÍSTICAS
- Formato de bolsillo: Portátil y fácil de transportar para acceder a la información en cualquier momento y lugar.
- Contenidos actualizados: Revisión exhaustiva de todos los contenidos para ofrecer un enfoque práctico y contextualizado de los conceptos teóricos.
- División en dos apartados principales: Microbiología general y Microbiología clínica, que abordan tanto los microorganismos patógenos como los síndromes clínicos infecciosos.
- Dirigido a estudiantes de Medicina y profesionales de la salud: Adecuado para aquellos que buscan una comprensión profunda de la microbiología.
- Colaboración multidisciplinaria: Participación de un grupo de destacados docentes de diferentes universidades españolas para ofrecer una visión representativa y actualizada de la microbiología en el ámbito académico.
DETALLES TÉCNICOS
- Autor: Profesor Picazo y Dr. Prieto
- EAN: 9788490229217
- Editorial: Sección de Microbiología Clínica de la UCM
- Número de páginas: Variable según la edición
- Idioma: Español
Esta nueva edición del Compendio de Microbiología es la herramienta perfecta para aquellos interesados en profundizar en el fascinante mundo de los microorganismos y su relevancia en la salud humana. Con un enfoque didáctico y actualizado, este libro ofrece una visión integral de la microbiología, respaldada por la experiencia y el prestigio de sus autores y colaboradores. ¡Sumérgete en el estudio de la microbiología con esta guía práctica y completa!